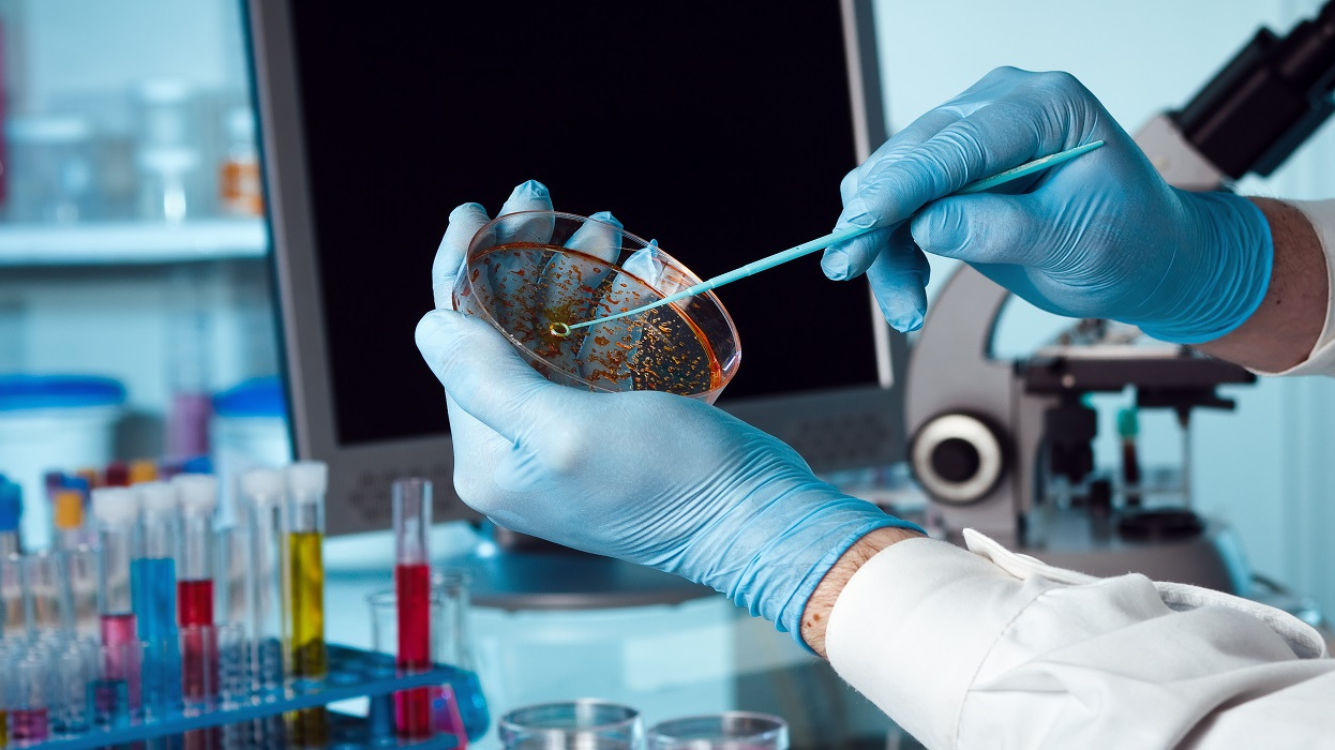

- Measures blood glucose levels at any given time of the day, regardless of when you last ate. It's a crucial test for monitoring diabetes.
- Measures blood glucose levels after fasting and after a meal. These tests help diagnose diabetes and monitor blood sugar control.
- A test to measure the body's ability to metabolize glucose, often used to diagnose gestational diabetes or other forms of diabetes.
- Includes several tests like urea and creatinine levels to assess how well your kidneys are working.
- Measures the amount of urea nitrogen in the blood, an important indicator of kidney function.
- A waste product measured to assess kidney function. Elevated levels may indicate impaired kidney function.
- Helps diagnose conditions related to abnormal uric acid levels, such as gout or kidney stones.
- A long-term measure of blood glucose levels over the past 2-3 months, crucial for managing diabetes.
- Tests the balance of electrolytes like sodium, potassium, and chloride in the blood, vital for heart, nerve, and muscle function.
- A panel of tests to assess liver health, including enzymes and proteins produced by the liver.
- Measures bilirubin levels to check for liver disease or bile duct obstruction.
- An enzyme found in the liver and heart. Elevated levels may indicate liver damage or heart issues.
- An enzyme mainly found in the liver. Elevated levels often indicate liver damage.
- An enzyme related to the liver and bones, elevated levels could indicate liver disease or bone disorders.
- A protein made by the liver, low levels may indicate liver or kidney disease.
- Measures the total amount of protein in the blood, which includes albumin and globulin. Abnormal levels can indicate kidney or liver disease.
- An enzyme that helps detect liver disease, especially alcohol-related liver damage.
- An enzyme produced by the pancreas to help digest carbohydrates, elevated levels may indicate pancreatic disease.
- An enzyme also produced by the pancreas to help digest fats, used to diagnose pancreatic disorders.
- A waste product formed by bacteria in the intestines, elevated levels may indicate liver dysfunction or metabolic disorders.
- Measures the amount of calcium in the blood, essential for bone health, muscle function, and nerve signaling.
- A group of tests measuring cholesterol and triglyceride levels to assess the risk of cardiovascular disease.
- Measures the total amount of cholesterol in your blood, important for assessing heart disease risk.
- Measures the amount of triglycerides in the blood, elevated levels may increase the risk of heart disease.
- Known as "good" cholesterol, high levels reduce the risk of heart disease.
- Measures the level of rheumatoid factor in the blood, used to diagnose rheumatoid arthritis and other autoimmune diseases.
- Measures the level of CRP in the blood, an indicator of inflammation in the body, often used to assess the risk of heart disease or to monitor inflammatory conditions.
Want to book this service? Fill out the contact form, and we'll get back to you as soon as possible!